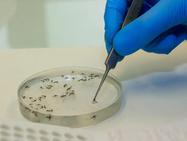
teaser image

Doença é transmitida pelo mosquito maruim e tem sintomas parecidos com os de outras arboviroses, como a dengue

A febre oropouche, transmitida pelo mosquito maruim, já soma 636 casos confirmados no Ceará, entre janeiro e o início de junho deste ano. Do total, três infecções foram registradas em gestantes, grupo monitorado por autoridades de saúde. Nenhuma morte foi contabilizada.
Os dados são da Secretaria Estadual da Saúde (Sesa), e mostram que, semanalmente, novos casos da arbovirose têm sido notificados, ainda que em velocidade menor do que no início do ano. A exceção foi a semana entre 8 e 14 de junho, que não teve novas notificações.
Desde o surgimento da doença no Estado, em 2024, a circulação da oropouche está restrita à região do Maciço de Baturité, no Ceará.
Veja também
No ano passado, Aratuba e Capistrano tiveram os maiores números de casos, com 67 e 64 notificações, respectivamente. Já em 2025, o cenário mudou.
Baturité lidera em número de infecções pelo vírus oropouche: sete em cada dez pessoas que contraíram a arbovirose são da cidade. No total, até 14 de junho, 438 casos foram confirmados lá.
Já Aratuba, localizada a cerca de 92 km de Fortaleza, ocupa o segundo lugar, com 121 notificações.
Cidades do Ceará com casos de febre oropouche em 2025:
- Baturité – 438
- Aratuba – 121
- Mulungu – 29
- Guaramiranga – 20
- Capistrano – 14
- Pacoti – 11
- Redenção – 2
- Aracoiaba – 1
Os casos de febre oropouche no Ceará entre janeiro e junho de 2025 são mais que o dobro dos contabilizados em todo o ano de 2024, quando 254 pessoas testaram positivo para a arbovirose, a primeira delas em julho.
Essa diferença é atribuída à migração do vírus para áreas que, anteriormente, não haviam sido afetadas – como a zona urbana de Baturité –, conforme explicou ao Diário do Nordeste, ainda em abril, o secretário Executivo de Vigilância da Sesa, Antonio Lima Neto.
Gestantes e oropouche
No ano passado, o Ceará registrou um óbito fetal decorrente da infecção da mãe pelo vírus oropouche. As gestantes, assim, são prioridade no monitoramento da doença realizado pelas autoridades de saúde.
Neste ano, três mulheres grávidas contraíram a febre oropouche. De acordo com a Sesa, todas são de Baturité.
Sintomas da febre oropouche
O diagnóstico da febre oropouche, que tem sintomas muito similares a outras arboviroses, como dengue, é feito por teste laboratorial. O Ministério da Saúde considera suspeitos casos com febre de mais de 5 dias, dor de cabeça forte e dois ou mais dos sintomas:
- Dor no corpo;
- Calafrios;
- Fotofobia (sensibilidade à luz);
- Tontura;
- Dor atrás dos olhos;
- Náuseas, vômitos ou diarreia;
- Meningoencefalite (inflamação no sistema nervoso), em casos graves;
- Manifestações hemorrágicas, em casos graves.
Como prevenir a febre oropouche
Apesar de causar sintomas parecidos com a dengue, as formas de prevenção são diferentes. A chave da proteção contra a oropouche não é o combate ao mosquito maruim, diferentemente do que ocorre em relação ao Aedes aegypti.
A melhor forma de prevenção é evitar o contato com o vetor, por meio de medidas individuais e coletivas, como:
- Evitar o contato com áreas de ocorrência e/ou minimizar a exposição às picadas dos vetores (mosquitos);
- Usar roupas que cubram a maior parte do corpo, como mangas compridas, calças e sapatos fechados;
- Aplicar repelente nas áreas expostas da pele;
- Limpar terrenos e locais de criação de animais;
- Recolher folhas e frutos que caem no solo;
- Usar telas de malha fina em portas e janelas.
“Uma das coisas importantes é que o culicoides, ao contrário do Aedes, não está dentro de casa. Ele vai pras varandas, procura as pessoas, e volta pro meio ambiente. A fêmea do Aedes vive conosco, procurando recipientes dentro de casa”, diferencia o secretário da Sesa.
Tanta reforça que “o futuro do controle da febre oropouche é a capacidade de bloqueio da entrada do mosquito em casa”.

Adcionar comentário